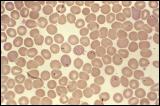

Babesiose (Ausführliche Info)
|
Tierärztliche Praxis für Kleintiere & Tierphysiotherapie Wandsbeker Zollstraße 11 22041 Hamburg |
Telefon 040. 75 11 80 40 Telefax 040. 75 11 80 41 www.tierarztpraxis-wandsbek.de www.tierphysiovet.de |
Ätiologie , Epidemiologie, Pathogenese, Klinik, Diagnose, Behandlung, Prophylaxe
Ätiologie
Babesiose ist eine Infektionskrankheit durch Einzeller der Gattung Sporozoa.
Diese befallen die Erythrozyten, zerstören diese und rufen dadurch eine Anämie hervor. Die Erkrankung verläuft in Deutschland meistens akut mit hohem Fieber und endet ohne Behandlung binnen weniger Tage tödlich.
Die Übertragung erfolgt vorwiegend durch Zecken. Babesiose kommt weltweit bei verschiedenen Tierarten in den warmen Klimazonen vor. Die verschiedenen Babesia-Spezies unterscheiden sich durch ihre Pathogenität und Verbreitung. Andere Tierarten oder der Mensch sind durch die beim Hund krankheitsauslösenden Babesien nicht gefährdet.
- Babesia canis, Subspezies Babesia canis canis, Hund, Europa mit Deutschland; Vektor ist Dermacentor reticulatus (Auwaldzecke)
- Babesia canis vogeli, Hund, Südeuropa; Vektor Rhipicephalus sanguineus (Braune Hundezecke)
- Babesia canis rossi, Hund, Afrika; Vektor Haemophyslis leachi.
Zu den bedeutsamen kleinen Babesien gehören:
- Babesia gibsoni, Asien, USA
Die Pathogenität der einzelnen Babesienstämme ist sehr unterschiedlich. Kleine Babesien wie B. gibsoni sind weniger pathogen als Babesia canis, verursachen weniger starke Symptome, sind aber andererseits schwerer nachweisbar und sind auch schwerer zu behandeln. Im Gegensatz zu Babesia canis wird durch die Behandlung keine Erregerelemination erreicht und es kommt häufiger zu Rezidiven.
Epidemiologie
Babesiose galt lange als eine Krankheit, die Hunde nach Reisen ins Ausland mitbrachten. Inzwischen ist die Zecke Dermacentor reticulatus (Auwaldzecke) in verschiedenen Regionen von Deutschland heimisch geworden. Nachdem zunächst nur am Oberrhein ortsständige Infektionen beobachtet wurden, gibt es mittlerweile Enzootiegebiete im Saarland, in Rheinland-Pfalz, in den Isarauen bei München, in der Umgebung von Regensburg, in den Elbauen und in Brandenburg.
Pathogenese
Nach einem Zeckenstick dauert es etwa 48 bis 72 Stunden, unter experimentellen Bedingungen nur bis zu 12 Stunden bis zu einer Übertragung der Babesien.
Durch das Anheften der Zecke an den Wirt werden durch Reizung des Nervensystems die in verschiedenen Organen ruhenden Sporozoiten aktiviert und entwickeln sich zu Kineten, die dann in die Speicheldrüsen einwandern und mit dem Zeckenspeichel in den Blutkreislauf des Hundes gelangen.
Die Sporozoiten dringen in die roten Blutkörperchen (Erythrozyten) der Hunde ein und vollziehen eine ungeschlechtliche Vermehrungsphase (Merogonie). Die dabei entstehenden Entwicklungsstadien (sogenannte Merozoiten) führen zu einer Schädigung der Erythrozyten, werden nach deren Zerstörung freigesetzt und können dann wiederum in neue, noch nicht befallene Erythrozyten eindringen.
Zecken nehmen bei einem Saugakt die befallenen Erythrozyten auf. Im Zeckendarm entwickeln sich die Merozoiten zu geschlechtlichen Babesienstadien (Gamonten und Gameten). Diese differenzieren sich zu Kineten, welche in die Eier innerhalb der Eierstöcke der Zecke eindringen und somit den Erreger auf die Zeckennachkommen weitergeben (transovarielle Übertragung). Durch diese transovarielle Übertragung sind nicht nur adulte Zecken, sondern auch Nymphen Babesienüberträger. Zudem wandern die Kineten in die Speicheldrüsen der Zecke, wo sie sich zu den für Hunde infektiösen Sporozoiten differenzieren.
Neben der Übertragung durch Zecken ist eine Infektion von Hund zu Hund über eine Bluttransfusion oder durch Blut-Blut-Kontakte – beispielsweise bei Beißereien – möglich. Auch eine Übertragung von der Hündin auf ihre Nachkommen („vertikale Infektion“) wird vermutet und ist für B. gibsoni nachgewiesen.
Klinik
Akute Form: Die Inkubationszeit beträgt 5 bis 7 Tage, selten kann sie bis zu drei Wochen nach dem Zeckenstich dauern. Krankheitszeichen (Symptome) sind ein gestörtes Allgemeinbefinden und Fieber, gefolgt von Fressunlust, Gewichtsverlust und Abgeschlagenheit. Ein bis zwei Tage später kommt es aufgrund des Zerfalls der roten Blutkörperchen (Hämolyse) zu Blutarmut (Anämie), Blutharnen, Ausscheidung des Blutfarbstoffabbauprodukts Bilirubin über den Harn (Bilirubinurie) und gegebenenfalls auch Gelbsucht. Eine Leber- und Milzvergrößerung kommt häufig vor. Bei schweren Verläufen treten eine Bauchwassersucht und Wasseransammlungen (Ödeme) sowie Haut- und Schleimhautblutungen infolge Blutplättchenmangel (Thrombozytopenie) und eine Blutgerinnung innerhalb der Blutgefäße (disseminierte intravasale Koagulopathie) auf. Entzündungen der Maul- (Stomatitis) und Magenschleimhaut (Gastritis) sowie der Muskulatur (Myositis) sind häufig.
Auch eine zentralnervöse Form mit epilepsieähnlichen Anfällen, Bewegungsstörungen und Lähmungen ist möglich. Die akute Form endet unbehandelt binnen weniger Tage mit dem Tod durch Atemnot, Anämie und Nierenversagen, welches eine gefürchtete Komplikation einer Babesiose ist.
Perakute Form: Der seltene perakute Verlauf endet ohne deutliche Symptome binnen ein bis zwei Tagen tödlich.
Die Infektion mit B. canis rossi verläuft ähnlich wie die mit B. canis canis. Der Grad der klinischen Erscheinungen hängt von verschiedenen Faktoren ab. In den klassischen Naturherden von Babesia canis canis (Südösterreich, Ungarn, Norditalien) sind die Jungtiere aufgrund einer hohen Durchseuchung im allgemeinen durch Antikörper aus der Erstmilch (Kolostrum) der Hündin geschützt, entwickeln durch primäre Latenz einen weitgehenden Schutz und werden zu immunen Überträgern. Hier dominiert der chronische oder subklinische Krankheitsverlauf mit unspezifischen Symptomen wie intermittierendem Fieber, Fressunlust, Blutarmut und allgemeiner Schwäche. Auch die Infektionen mit B. canis vogeli und den „kleinen Babesien“ verlaufen milder.
Diagnose
Da die Symptome auch auch bei anderen fieberhaften Krankheiten auftreten können, versucht der Tierarzt die Babesien direkt im Blut nachzuweisen. Werden die Babesien gefunden ist die Diagnose sicher. Antikörper können im akuten Stadium noch negativ sein, können nach etwa 10 Tagen nachgewiesen werden. Die Babesien können außerdem auch mittels einer PCR-Untersuchung nachgewiesen werden.
Babesien in Erythrozyten Klick auf Bild öffnet Bildquelle
Behandlung
Die Behandlung von Babesia-canis-Infektionen wird mit einem Medikament aus der Wirkstoffklasse der Carbanilide und Diamidinderivate durchgeführt. Der Wirkmechanismus ist zur Zeit noch nicht genau geklärt. Der Tierarzt muß das Medikament über die Internationale Apotheke bestellen.
Begleitend wird unterstützend behandelt, z.B. durch Infusionen oder auch Bluttransfusionen.
Prophylaxe
In Deutschland ist kein Impfstoff verfügbar. In einzelnen Fällen können Ausnahmegenehmigungen für die Verwendung von im europäischen Ausland zugelassenen Impfstoffen erteilt werden.
Die Impfung schützt nicht vor einer Infektion und der Entstehung der Krankheit, aber sie mildert die Schwere der Symptome ab.
Die wichtigste Prophylaxe ist die Zeckenprävention! Man kann das Medikament, welches zur Behandlung eingesetzt wird, auch prophylaktisch anwenden. Es bietet einen Schutz von ca. 3 Wochen.
(C) 2011 - Alle Rechte vorbehalten